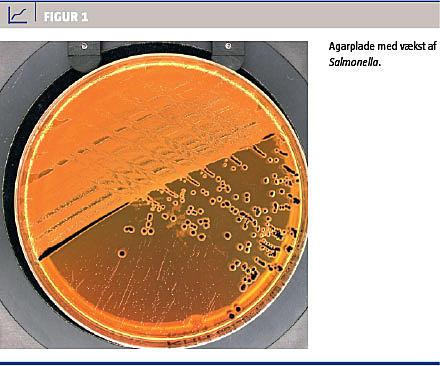

Nontyfoide Salmonella spp. er på verdensplan årsag til talrige tilfælde af gastroenteritis. I udviklingslande er disse bakterier også en vigtig årsag til invasive infektioner som bakteriæmi, meningitis og septisk artritis, især hos spædbørn og personer med konkurrerende sygdomme.
Invasiv sygdom forårsaget af Salmonella er sjælden i udviklede lande [1].
Vi præsenterer en sygehistorie med Salmonella enterica serovar Enteritidis (S. Enteritidis)-meningitis hos et ellers raskt spædbarn.
SYGEHISTORIE
En ti dage gammel pige, der var født til terminen, blev indlagt med feber gennem 16 timer, kraftig gråd og kliniske tegn på dehydrering. Fødslen og den postnatale periode havde været ukompliceret. Fødselsvægten var 3.238 g. Barnet blev ammet, og der blev suppleret med modermælkserstatning. Ved indlæggelsen var temperaturen 38,3 °C, det systoliske blodtryk 95 mmHg, pulsen 165/min, respirationsfrekvensen 78/min og saturationen 95% uden ilttilskud. Afføringen var normal. Initiale blodprøver viste flg. koncentrationer: hæmoglobin 13,4 mmol/l, natrium 135 mmol/l, kalium 4,5 mmol/l, C-reaktivt protein 26 mg/l og plasmaglukose 15,3 mmol/l; baseoverskud var -0,7 mmol/l og pH 7,31. Leukocytkoncentrationen og differentialtælling var inden for normalområdet.
På klinisk mistanke om sepsis blev der påbegyndt behandling med cefuroxim og gentamicin. I løbet af få timer blev barnet tiltagende irritabelt og takypnøisk med grålig hudfarve. Der blev foretaget lumbalpunktur og celletælling, og resultatet tydede på meningitis (Tabel 1).

Behandlingen blev ændret til meropenem og gentamicin. Dyrkning af cerebrospinalvæske (CSV) og blod viste efter et døgn vækst af S. Enteritidis (fuldt følsom for ampicillin, ceftriaxon, meropenem, ciprofloxacin, gentamicin og sulfamethizol). Lum-balpunktur, der blev gentaget på dag to, viste også vækst af S. Enteritidis (Figur 1).
Behandlingen med meropenem blev seponeret efter 16 dage og blev efterfulgt af ceftriaxon og ciprofloxacin i 14 dage. CSV-fundene ses i Tabel 1. Der var ingen vækst af patogene bakterier på dag 29 og 36. En ultralydskanning af cerebrum på dag otte og en audiologisk undersøgelse to måneder efter indlæggelsen viste normale forhold.
Patienten blev udskrevet efter 36 dage. Ved klinisk undersøgelse fem og 11 måneder senere blev der ikke fundet neurologiske sequelae. Vækstkurver for hovedomfang, højde og vægt var normale. Ingen i familien, bestående af far, mor, en 12-årig bror samt en hund, havde haft symptomer på sygdom. Dyrkning af brystmælk fra moderen og afføringsprøver fra alle familiemedlemmer viste ingen vækst af Salmonella spp. Familien havde ikke krybdyr. Årsagen til infektionen blev ikke fundet.
Diskussion
De hyppigst forekommende patogener ved bakteriel meningitis hos børn under en måned er gruppe B-streptokokker, Escherichia coli og Listeria monocytogenes [2], mens Salmonella-meningitis er sjælden hos små børn i udviklede lande [1]. Risikofaktorer for Salmonella-infektion er kontakt med krybdyr og kontakt med et andet barn med diare, mens amning beskytter mod infektion [3]. Anbefalet initiale empiriske antibiotika til behandling af meningitis hos børn under en måned er ampicillin og gentamicin eller cefotaxim, hvis der er mistanke om gramnegtive bakterier. Indførelsen af Haemophilus influenzae type B- og den konjugerede pneumokokvaccine har ført til reduktion af meningitis forårsaget af disse bakterier, også blandt uvaccinerede som følge af flokimmunitet [2], om end dette ikke er specifikt påvist for neonatale. En risikovurdering med henblik på hyppigheden af mere ualmindelige mikroorganismer som årsag til meningitis må indgå i valget af initial empirisk antibiotikabehandling.
I en tiårsopgørelse fra Malawi af nontyfoid Salmonella-meningitis hos børn fandt man et signifikant fald i forekomsten af sequelae blandt de overlevende og et fald i antal recidivtilfælde efter i alt fire ugers behandling med ceftriaxon og ciprofloxacin sammenlignet med to ugers behandling med chloramphenicol som monoterapi [4].
Kombinationsbehandling med et tredjegenerationscefalosporin og et fluoroquinolon eller eventuelt carbapenem anbefales af flere. Da bakterien er lokaliseret intracellulært, er gentagne lumbalpunkturer indiceret, og varigheden af behandling bør være mindst fire uger eller tre uger efter den første sterile CSV-prøve [5].
KORRESPONDANCE: Lotte Jensen, Pædiatrisk Afdeling, Hvidovre Hospital, Kettegård Allé 30, 2650 Hvidovre. E-mail: lottejensen@dadlnet.dk
ANTAGET: 23. oktober 2012
FØRST PÅ NETTET: 18. februar 2013
INTERESSEKONFLIKTER:
<div class="story story_litteratur" id="9E5A1B69-DBE0-4106-B7E9-A0A4CDBF4E7A">
<h2>LITTERATUR</h2>
<ol type="d">
<li><p>Graham SM. Salmonellosis in children in developing and developed countries and populations. Curr Opin Infect Dis 2002;15:507-12.</p></li>
<li><p>Kim KS. Acute bacterial meningitis in infants and children. Lancet Infect Dis 2010;10:32-42.</p></li>
<li><p>Marcus R. New information about pediatric foodborne infections: the view from FoodNet. Curr Opin Pediatr 2008;20:79-84.</p></li>
<li><p>Molyneux EM, Mankhambo LA, Phiri A et al. The outcome of non-typhoidal salmonella meningitis in Malawian children, 1997-2006. Ann Trop Paediatr 2009;29:13-22.</p></li>
<li><p>Price EH, de Louvois J, Workman MR. Antibiotics for Salmonella meningitis in children. J Antimicrob Chemother 2000;46:653-5.</p></li>
</ol>
</div>